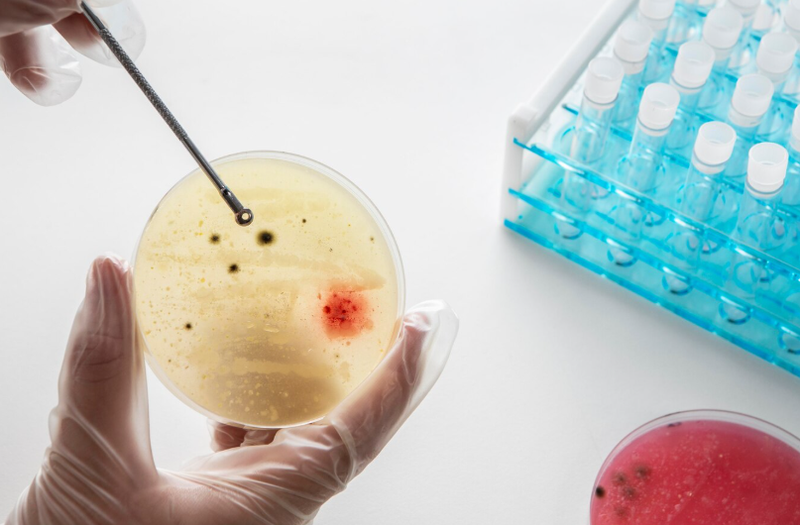
Xét nghiệm tinh dịch đồ có cần thiết không? Những điều cần biết về xét nghiệm tinh dịch đồ 1

Dược sĩ Đại học có nhiều năm kinh nghiệm trong việc tư vấn Dược phẩm và hỗ trợ giải đáp thắc mắc về Bệnh học. Hiện đang là giảng viên cho Dược sĩ tại Nhà thuốc Long Châu.
Ngọc Diễm
05/08/2025
Mặc định
Lớn hơn
Trong hành trình tìm kiếm cơ hội làm cha, nhiều nam giới vẫn còn ngần ngại hoặc chưa thực sự hiểu rõ vai trò của xét nghiệm tinh dịch đồ. Đây là một xét nghiệm đơn giản nhưng có giá trị quan trọng trong việc đánh giá chất lượng tinh trùng và khả năng sinh sản của phái mạnh. Hãy cùng chúng tôi tìm hiểu chi tiết hơn về xét nghiệm tinh dịch đồ và một số thông tin liên quan nhé!
Để hiểu rõ hơn về tầm quan trọng của xét nghiệm tinh dịch đồ, trước hết chúng ta cần biết xét nghiệm này là gì, được thực hiện như thế nào và kết quả mang lại những thông tin gì về sức khỏe sinh sản của nam giới. Bên cạnh đó, việc nắm được các yếu tố ảnh hưởng đến kết quả xét nghiệm cũng giúp quá trình đánh giá chính xác và hiệu quả hơn.
Xét nghiệm tinh dịch đồ là một phương pháp cận lâm sàng được sử dụng để phân tích chất lượng và số lượng tinh trùng trong tinh dịch của nam giới. Dưới đây là quy trình xét nghiệm tinh dịch đồ mà các bạn nam cần lưu ý:
Xét nghiệm tinh dịch đồ được thực hiện nhằm đánh giá sức khỏe sinh sản ở nam giới thông qua việc phân tích các đặc điểm của tinh trùng và tinh dịch. Cụ thể, mục đích của xét nghiệm như:
Xét nghiệm tinh dịch đồ thường được chỉ định trong các trường hợp sau:
Xét nghiệm tinh dịch đồ cung cấp nhiều thông tin giúp đánh giá chất lượng tinh trùng và khả năng sinh sản của nam giới. Dưới đây là những chỉ số quan trọng nhất trong xét nghiệm tinh dịch đồ các bạn nam nên chú ý:

Để xét nghiệm tinh dịch đồ cho kết quả chính xác, phản ánh đúng tình trạng sức khỏe sinh sản của nam giới, việc chuẩn bị đúng cách là vô cùng quan trọng. Không ít trường hợp kết quả bị sai lệch chỉ vì chủ quan trong khâu chuẩn bị hoặc không tuân thủ hướng dẫn sau khi thực hiện. Dưới đây là những điểm nam giới cần đặc biệt ghi nhớ để đảm bảo hiệu quả và độ tin cậy của kết quả xét nghiệm.
Trước khi tiến hành xét nghiệm tinh dịch đồ, nam giới cần chuẩn bị đúng cách để đảm bảo kết quả phản ánh chính xác chất lượng tinh trùng. Một số yếu tố tưởng chừng đơn giản nhưng nếu bỏ qua có thể ảnh hưởng đến độ tin cậy của xét nghiệm:
Sau khi thực hiện xét nghiệm, nam giới cần chú ý đến cách hiểu kết quả và những bước tiếp theo để có hướng xử lý phù hợp nếu phát hiện bất thường:

Xét nghiệm tinh dịch đồ không chỉ dành cho nam giới gặp vấn đề về sinh sản mà còn hữu ích trong nhiều tình huống khác. Dưới đây là những đối tượng nên thực hiện xét nghiệm này bao gồm:
Tinh trùng có thể thay đổi theo thời gian và bị ảnh hưởng bởi nhiều yếu tố như sức khỏe, thói quen sinh hoạt, căng thẳng hoặc dùng thuốc. Vì vậy, trong các trường hợp sau, cần xét nghiệm lại:

Xét nghiệm tinh dịch đồ là một bước quan trọng và cần thiết trong việc đánh giá khả năng sinh sản của nam giới, đặc biệt với những cặp vợ chồng đang mong con nhưng gặp khó khăn trong thụ thai. Việc hiểu rõ quy trình, các chỉ số và thời điểm nên thực hiện không chỉ giúp bạn chủ động hơn trong việc chăm sóc sức khỏe sinh sản mà còn là nền tảng để phát hiện sớm những bất thường tiềm ẩn.
Dược sĩ Đại họcNguyễn Mỹ Huyền
Dược sĩ Đại học có nhiều năm kinh nghiệm trong việc tư vấn Dược phẩm và hỗ trợ giải đáp thắc mắc về Bệnh học. Hiện đang là giảng viên cho Dược sĩ tại Nhà thuốc Long Châu.